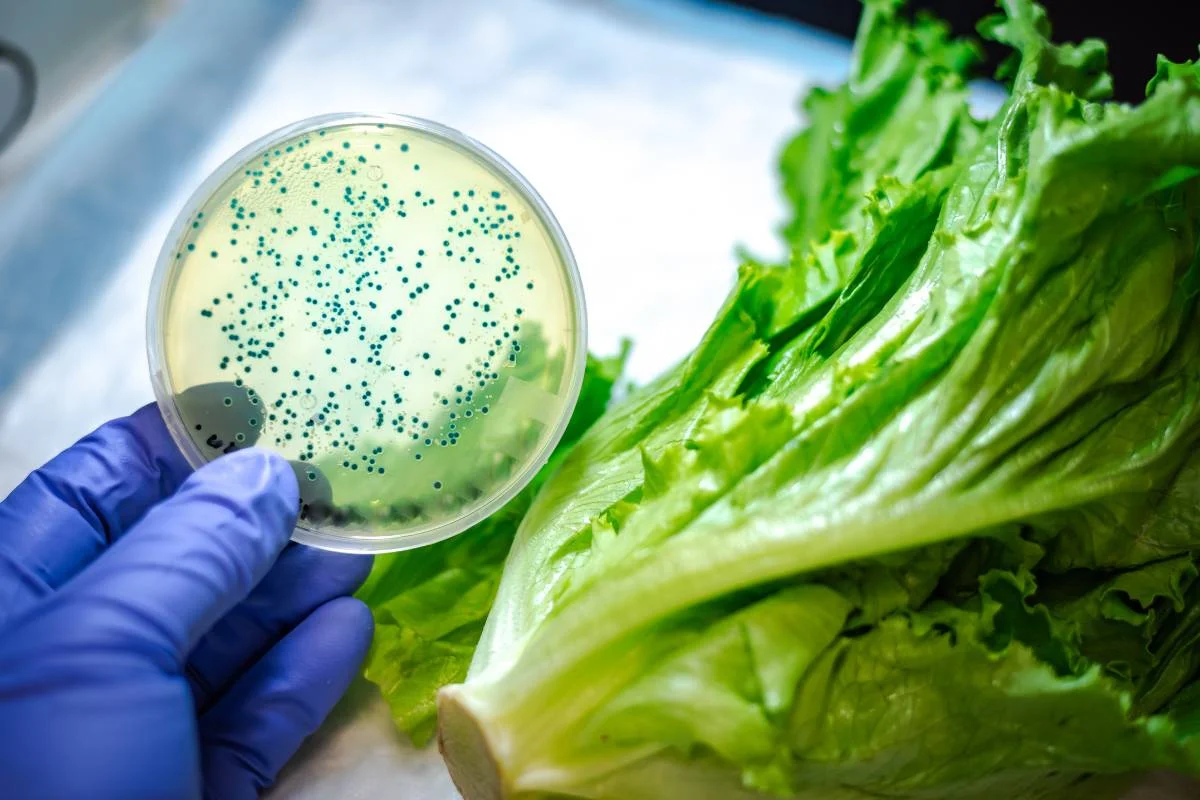
food-poisoning

Food poisoning spreads through contaminated food and causes symptoms like nausea, vomiting, and diarrhea. Liv Hospital provides fast diagnosis and effective treatment.
Send us all your questions or requests, and our expert team will assist you.
Symptoms and Transmission of Food Poisoning
Understanding the Symptoms and Transmission of food poisoning is essential for anyone who travels, dines out, or prepares meals at home. Each year, millions of people worldwide experience foodborne illnesses, and early recognition can dramatically reduce complications. This page provides a comprehensive overview for international patients and travelers, detailing how food poisoning manifests, the ways harmful pathogens spread, and practical steps to protect your health.
From mild stomach upset to severe dehydration, the range of clinical presentations can be wide. By familiarizing yourself with the typical signs and the most common routes of transmission, you can act quickly and seek appropriate medical care—services that Liv Hospital offers with a dedicated international patient team.
Below, we explore the core aspects of foodborne disease, focusing on the interplay between clinical symptoms and the mechanisms of transmission, while offering evidence‑based guidance for prevention and treatment.
Common Symptoms of Food Poisoning

Foodborne illnesses often begin abruptly, typically within hours after consuming contaminated food. While the exact presentation depends on the offending pathogen, several hallmark signs recur across most cases.
Key clinical features include:
These symptoms usually last between 24 to 72 hours, but some infections, such as those caused by Salmonella or Campylobacter, can persist longer. In vulnerable populations—children, the elderly, pregnant women, and immunocompromised individuals—the illness can progress rapidly, leading to severe dehydration or systemic infection.
Recognizing the pattern of symptoms and transmission helps differentiate food poisoning from other gastrointestinal conditions. For instance, the sudden onset of vomiting followed by watery diarrhea is more characteristic of bacterial toxins, whereas a gradual increase in abdominal pain may suggest a parasitic infection.
How Food Poisoning Is Transmitted
Transmission pathways are diverse, reflecting the variety of microorganisms that cause foodborne disease. Understanding these routes enables targeted prevention strategies, especially for travelers who encounter unfamiliar food handling practices.
Transmission Route | Typical Sources | Common Pathogens |
|---|---|---|
Improper Cooking | Undercooked meat, poultry, eggs | Salmonella, Campylobacter |
Cross‑Contamination | Cutting boards, utensils, raw‑to‑cooked contact | E. coli, Listeria |
Contaminated Water | Unpasteurized dairy, ice, irrigation water | Vibrio, Giardia |
Improper Storage | Temperature‑abused leftovers, buffet dishes | Staphylococcus aureus, Bacillus cereus |
Human Handlers | Food service staff with poor hygiene | Norovirus, Hepatitis A |
Each transmission route aligns with specific risk factors. For example, foods left at ambient temperature for more than two hours provide an ideal environment for bacterial multiplication, amplifying the chance of infection. Likewise, inadequate hand washing can spread viral agents that cause acute gastroenteritis.
By linking the observed symptoms and transmission patterns, clinicians at Liv Hospital can swiftly identify the likely source and initiate appropriate therapy, such as rehydration, antimicrobial treatment, or supportive care.
High‑Risk Foods and Situations
Not all foods carry the same level of danger. Certain items are repeatedly implicated in outbreaks due to their intrinsic properties or typical handling practices.
Situational risk factors amplify exposure:
Being aware of these high‑risk foods and scenarios enables you to make informed choices, reducing the likelihood of encountering the symptoms and transmission cycle of foodborne illness.

Prevention Strategies for International Travelers
Travel introduces unique challenges, but simple, evidence‑based habits can dramatically lower your risk of food poisoning.
Key preventive measures:
Travelers who follow these steps significantly reduce exposure to the agents responsible for the symptoms and transmission of food poisoning. Should you develop concerning signs while abroad, Liv Hospital’s international patient service can coordinate remote consultations and arrange safe repatriation if needed.
When to Seek Medical Care
Most cases of food poisoning resolve with self‑care, but certain red‑flag signs warrant immediate medical attention to prevent severe complications.
Warning Sign | Why It Matters | Recommended Action
|
|---|---|---|
Persistent vomiting (>24 hours) | Risk of dehydration and electrolyte imbalance | Seek urgent care for IV fluids |
Bloody diarrhea | Possible invasive bacterial infection | Medical evaluation for antibiotics |
High fever (≥ 38.5 °C) lasting >48 hours | Indicates systemic infection | Hospital assessment |
Severe abdominal pain | May signal organ involvement or perforation | Immediate emergency care |
Neurological symptoms (e.g., confusion, vision changes) | Rare but serious toxin‑mediated effects | Emergency department visit |
If you belong to a vulnerable group—children under five, pregnant women, the elderly, or individuals with chronic illnesses—consult a healthcare professional at the first sign of illness. Liv Hospital’s multilingual staff can arrange prompt evaluation, diagnostic testing, and tailored treatment plans, ensuring a swift recovery.
Why Choose Liv Hospital
Liv Hospital combines JCI accreditation with a dedicated international patient program, offering seamless coordination from appointment scheduling to post‑treatment follow‑up. Our multidisciplinary teams specialize in infectious diseases, gastroenterology, and critical care, ensuring you receive evidence‑based treatment for food‑borne illnesses. With 24/7 interpreter services, airport transfers, and comfortable accommodation options, we make your health journey as stress‑free as possible.
Ready to protect your health or need expert care for food poisoning? Contact Liv Hospital today to schedule a consultation with our infectious‑disease specialists. Our international patient coordinators are standing by to assist you with every step of your medical journey.

Send us all your questions or requests, and our expert team will assist you.
Food poisoning usually begins abruptly within hours after eating contaminated food. The most frequent signs are nausea and vomiting, which may be followed by abdominal cramps or pain. Diarrhea can be watery or bloody, and a low‑grade fever often accompanies the gastrointestinal upset. Some patients also experience headache, muscle aches, and general weakness. Symptoms generally last 24 to 72 hours, but certain pathogens like Salmonella or Campylobacter may cause longer illness, especially in vulnerable groups such as children, the elderly, pregnant women, and immunocompromised individuals.
Transmission routes reflect the diversity of foodborne microorganisms. Undercooked meat, poultry, or eggs can harbor Salmonella and Campylobacter, while cross‑contamination on cutting boards spreads E. coli and Listeria. Contaminated water, including unpasteurized dairy or ice, introduces Vibrio and Giardia. Improper storage at ambient temperatures encourages growth of Staphylococcus aureus and Bacillus cereus. Finally, food handlers with inadequate hand hygiene can transmit Norovirus and Hepatitis A. Recognizing these pathways helps target prevention measures, especially for travelers encountering unfamiliar food practices.
Certain foods are repeatedly linked to outbreaks because of their intrinsic properties or handling. Raw or undercooked shellfish can contain Vibrio species, while unpasteurized dairy products such as soft cheeses may harbor Listeria. Leafy greens and sprouts can be contaminated through irrigation water. Ready‑to‑eat meats like deli slices and hot dogs can become dangerous if not reheated properly. Street‑food vendors often lack consistent temperature control and hygiene, increasing the chance of bacterial or viral contamination. Avoiding or carefully preparing these items reduces infection risk.
Travelers should prioritize foods that are thoroughly cooked and served hot, ensuring meat, poultry, and eggs reach safe internal temperatures. Drinking bottled or treated water eliminates risks from contaminated tap sources. Fresh fruits and vegetables should be washed with clean water or peeled when possible. Hand hygiene—washing with soap or using alcohol‑based sanitizer—prevents viral spread. Selecting street‑food stalls with visible cleanliness and high turnover reduces exposure. Finally, refrigerate leftovers within two hours and reheat to at least 75 °C (165 °F) to destroy residual pathogens. Consistently applying these habits markedly lowers the chance of foodborne illness.
While most cases resolve with home care, red‑flag signs demand immediate medical attention. Persistent vomiting lasting more than 24 hours risks dehydration and electrolyte imbalance, requiring IV fluids. Bloody diarrhea suggests an invasive bacterial infection that may need antibiotics. A fever of 38.5 °C or higher persisting beyond 48 hours indicates systemic involvement. Severe abdominal pain could signal organ damage or perforation, and neurological symptoms such as confusion point to toxin‑mediated effects. Vulnerable individuals—children, pregnant women, the elderly, or those with chronic illnesses—should contact healthcare providers at the first sign of illness. Liv Hospital offers international patient support and can arrange urgent evaluation.

 Food Poisoning
Food Poisoning Food Poisoning
Food Poisoning Food Poisoning
Food Poisoning Food Poisoning
Food Poisoning Food Poisoning
Food Poisoning Food Poisoning
Food Poisoning
Leave your phone number and our medical team will call you back to discuss your healthcare needs and answer all your questions.
Your Comparison List (you must select at least 2 packages)